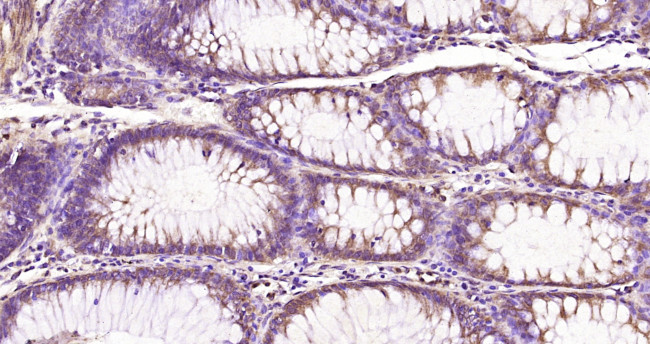
Nemo-like kinase Antibody in Immunohistochemistry (Paraffin) (IHC (P))

Search
Bioss
Nemo-like kinase Polyclonal Antibody
{{$productOrderCtrl.translations['antibody.pdp.commerceCard.promotion.promotions']}}
{{$productOrderCtrl.translations['antibody.pdp.commerceCard.promotion.viewpromo']}}
{{$productOrderCtrl.translations['antibody.pdp.commerceCard.promotion.promocode']}}: {{promo.promoCode}} {{promo.promoTitle}} {{promo.promoDescription}}. {{$productOrderCtrl.translations['antibody.pdp.commerceCard.promotion.learnmore']}}
图: 1 / 1
Nemo-like kinase Antibody (BS-10420R) in IHC (P)

产品信息
BS-10420R
种属反应
宿主/亚型
分类
类型
抗原
偶联物
形式
浓度
规格
纯化类型
保存液
内含物
保存条件
运输条件
靶标信息
NLK is a serine/threonine kinase involved in signal transduction and cellular communication. Positive effector of the non-canonical Wnt signaling pathway, acting downstream of WNT5A, MAP3K7/TAK1 and HIPK2. Activation of this pathway causes binding to and phosphorylation of the histone methyltransferase SETDB1. The NLK-SETDB1 complex subsequently interacts with PPARG, leading to methylation of PPARG target promoters at histone H3K9 and transcriptional silencing. The resulting loss of PPARG target gene transcription inhibits adipogenesis and promotes osteoblastogenesis in mesenchymal stem cells (MSCs). Negative regulator of the canonical Wnt/beta-catenin signaling pathway. Binds to and phosphorylates TCF7L2/TCF4 and LEF1, promoting the dissociation of the TCF7L2/LEF1/beta-catenin complex from DNA, as well as the ubiquitination and subsequent proteolysis of LEF1. Together these effects inhibit the transcriptional activation of canonical Wnt/beta-catenin target genes. Negative regulator of the Notch signaling pathway. Binds to and phosphorylates NOTCH1, thereby preventing the formation of a transcriptionally active ternary complex of NOTCH1, RBPJ/RBPSUH and MAML1. Negative regulator of the MYB family of transcription factors.
仅用于科研。不用于诊断过程。未经明确授权不得转售。
篇参考文献 (0)
生物信息学
蛋白别名: Nemo-like kinase; NLK; Protein LAK1; serine/threonine protein kinase NLK; Serine/threonine-protein kinase NLK; similar to mouse nemo-like kinase (Nlk); unnamed protein product
基因别名: AI194375; LAK1; NLK; RGD1561602
UniProt ID: (Human) Q9UBE8, (Mouse) O54949, (Rat) D3ZSZ3
Entrez Gene ID: (Human) 51701, (Mouse) 18099, (Rat) 497961